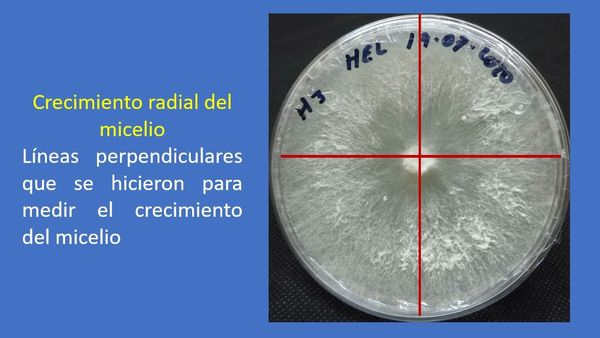
CLY487 - Aislamiento de una cepa del hongo comestible Hericium erinaceus para su cultivo en residuo…

Celaya 2021 Congreso Virtual
CLY468 - Estrategias de Cultura Organizacional para el Cumplimiento de Programas Internos en una In…
CLY472 - Lanzamiento de un Nuevo Sello Automotriz para Motores a Gasolina para Aumentar el Desarrol…
CLY484 - Realidad Virtual en Favor de la Calidad de Vida en Personas con Riesgo de Padecer Alzheimer
CLY487 - Aislamiento de una cepa del hongo comestible Hericium erinaceus para su cultivo en residuo…
CLY489 - Uso de Estrategias Contables y Financieras de las Mipymes del Valle de Mexicali, Baja Cali…
CLY490 - EXPERIENCIAS DE APRENDIZAJE APOYADO EN TIC EN EL MARCO DE LA EMERGENCIA SANITARIA POR COVI…
CLY503 - La Resiliencia y el Estado Funcional en Adultos Mayores con Diabetes Mellitus Tipo 2, Hosp…